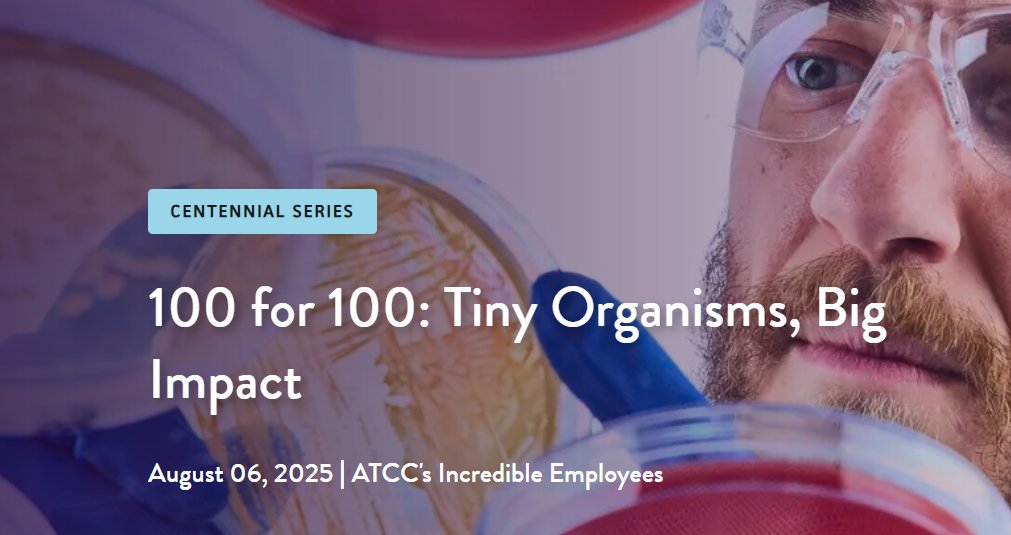

ATCC
@officialatcc
ATCC is a premier global biological materials and standards organization and the leading developer and supplier of credible biological materials and data.
ID: 2244566827
http://www.atcc.org 13-12-2013 21:59:21
2,2K Tweet
1,1K Followers
174 Following